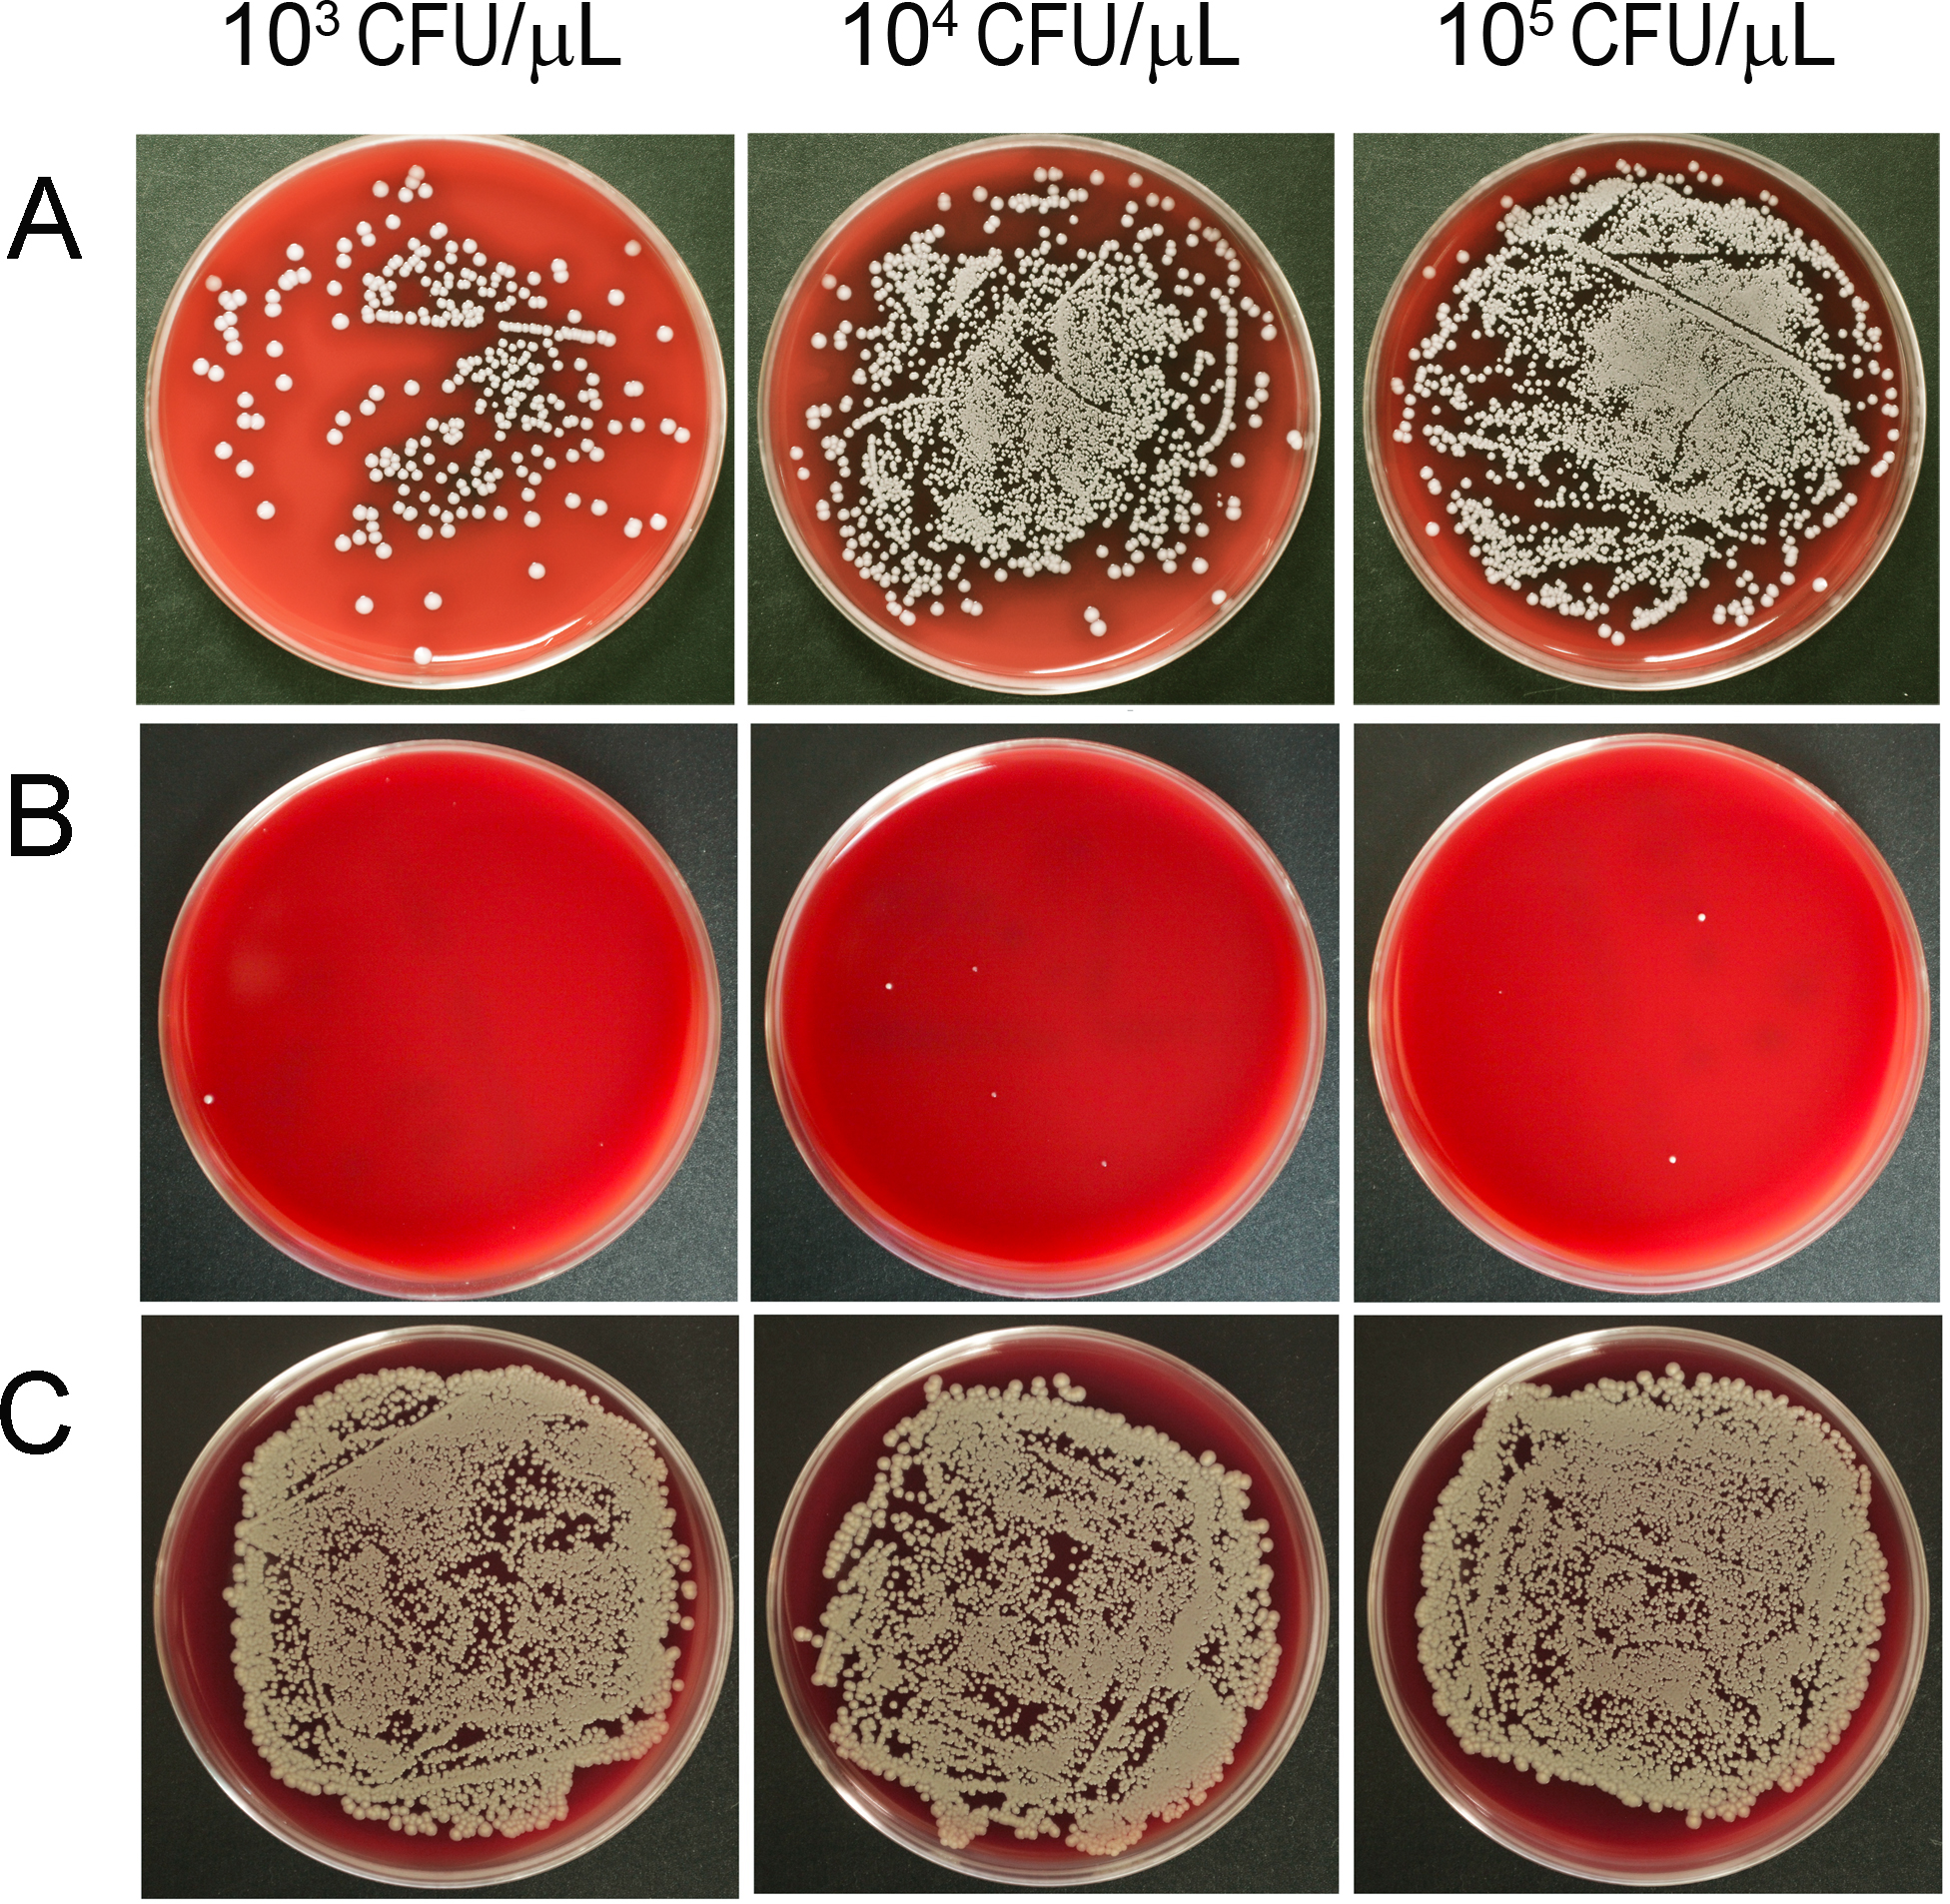

Figure 4. Culture plates of the separations of porcine vitreous inoculated with Staphylococcus aureus. After homogenization and centrifugation, the vitreous lysates (A, 50 μl of 100X lysate), supernatant (B, 50 μl of 100X solution), and pellet (C, 50 μl of 10X resuspension) were smeared on blood agar plates and incubated for 24 h. Few colonies were identified in the
supernatant samples across all concentrations of S. aureus.